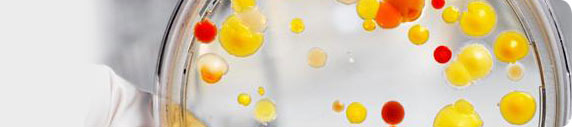
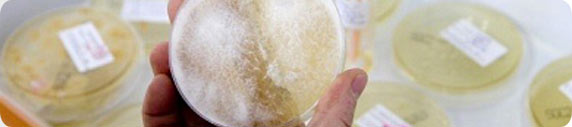

mikrobiologie labor technik distributie
- HOME
- PRODUSE
- Medii turnate in placi Petri - producator MLT
- Medii turnate in tuburi - producator MLT
- Medii turnate in sticle - producator MLT
- Medii deshidratate
- Suplimente pentru medii
- Reactivi si seruri latex pentru identificare microbiana
- Discuri antibiograma / antifungigrama
- Tulpini de referinta
- Sisteme biochimice de identificare si/sau antibiograma
- Teste rapide
- Coloratii
- Dip-Slide
- CONS-LAB - divizia de consumabile pentru laborator
- Reactivi imunologie, etc.
- Controale sterilizare
- Diverse
- COSUL MEU
- CUM CUMPAR
- DESPRE NOI
- CONTACT
CAUTARE


CATEGORII
- Medii turnate in placi Petri - producator MLT
- Medii turnate in tuburi - producator MLT
- Medii turnate in sticle - producator MLT
- Medii deshidratate
- Suplimente pentru medii
- Reactivi si seruri latex pentru identificare microbiana
- Discuri antibiograma / antifungigrama
- Tulpini de referinta
- Sisteme biochimice de identificare si/sau antibiograma
- Teste rapide
- Coloratii
- Dip-Slide
- CONS-LAB - divizia de consumabile pentru laborator
- Reactivi imunologie, etc.
- Controale sterilizare
- Diverse
CERTIFICATE
Pentru vizualizarea certificatelor de control, va rugam sa specificati codul produsului si lotul, informatii inscrise pe ambalajul produselor.
NEWSLETTER
Medii turnate in placi Petri - producator MLT
- sunt medii cu agar folosite pentru identificarea si testarea sensibilitatii germenilor patogeni.
Medii turnate in tuburi - producator MLT
- sunt medii lichide sau solide folosite pentru imbogatirea culturii si/sau identificarea germenilor patogeni.
Medii turnate in sticle - producator MLT
- mediile gata preparate sunt ambalate in sticle pentru a creste perioada lor de valabilitate.
Medii deshidratate
- mediile de cultura deshidratate sunt utilizate pentru prepararea mediilor gata de utilizare.
Suplimente pentru medii
- sunt substante chimice, antibiotice, etc. necesare pentru prepararea unor medii de cultura.
Reactivi si seruri latex pentru identificare microbiana
- sunt substante folosite pentru identificarea microorganismului cercetat.
Discuri antibiograma / antifungigrama
- utilizate pentru testarea sensibilitatii la antibiotice / antifungice a micro-organismelor.
Sisteme biochimice de identificare si/sau antibiograma
- identificare si ATB direct din probele biologice
- identificare si ATB
- identificare microbiana
- antibiograma
- identificare si ATB
- identificare microbiana
- antibiograma
Teste rapide
- obstetrica/fertilitate
- markeri cardio-vasculari, tumorali si markeri ai inflamatiei
- boli infectioase si autoimune
- urina, etc.
- markeri cardio-vasculari, tumorali si markeri ai inflamatiei
- boli infectioase si autoimune
- urina, etc.
CONS-LAB - divizia de consumabile pentru laborator
- articole din plastic
- articole din sticla
- articole din lemn
- articole din metal
- evidenta sterilizarii
- etc.
- articole din sticla
- articole din lemn
- articole din metal
- evidenta sterilizarii
- etc.
Controale sterilizare
© Mikrobiologie Labor-Technik 2011 - 2026